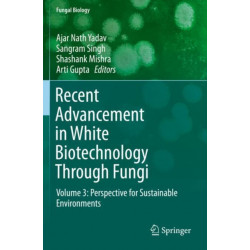
Recent Advancement in White Biotechnology Through Fungi: Volume 3: Perspective for Sustainable Environments

Ingen varer
Udviklingsbiologi
Visning: Type : Alle | Sprog : Alle | Format : Alle
-
Bemærk: Kan ikke leveres før jul.
Spinal Evolution: Morphology, Function, and Pathology of the Spine in Hominoid Evolution (Bog, Paperback / softback, Engelsk)The vertebral spine is a key element of the human anatomy. New and exciting finds, mostly from Europe and Africa, as well as new methods for reconstructing the spine, have been introduced to the research community.
Levering: Skaffevare (forvent 14 - 30 hverdage) -
Bemærk: Kan ikke leveres før jul.
The Golgi Apparatus and Centriole: Functions, Interactions and Role in Disease (Bog, Paperback / softback, Engelsk)Levering: Skaffevare (forvent 14 - 30 hverdage) -
Bemærk: Kan ikke leveres før jul.
Stem Cell Transplantation for Autoimmune Diseases and Inflammation (Bog, Paperback / softback, Engelsk)This book introduces many new technologies and clinical applications of hematopoietic stem cells and mesenchymal stem cell transplantation for the treatment of autoimmune diseases and inflammatory diseases.
Levering: Skaffevare (forvent 14 - 30 hverdage) -
Bemærk: Kan ikke leveres før jul.
Genetics and Genomics of Linum (Bog, Paperback / softback, Engelsk)The genus includes common flax, which is one of the best fibers to produce linen, the seeds to produce linseed oil and has health-related properties of flax in human and... Læs mere
Levering: Skaffevare (forvent 14 - 30 hverdage) -
Bemærk: Kan ikke leveres før jul.
Early Life Origins of Ageing and Longevity (Bog, Paperback / softback, Engelsk)Levering: Skaffevare (forvent 14 - 30 hverdage) -
Bemærk: Kan ikke leveres før jul.
Recent Advancement in White Biotechnology Through Fungi: Volume 3: Perspective for Sustainable Environments (Bog, Paperback / softback, Engelsk)This discovery was a milestone in the development of white biotechnology as the industrial production of penicillin and antibiotics using fungi moved industrial biotechnology into the modern era, transforming it into a global industrial technology.
Levering: Skaffevare (forvent 14 - 30 hverdage) -
Bemærk: Kan ikke leveres før jul.
Pluripotent Stem Cells in Eye Disease Therapy (Bog, Paperback / softback, Engelsk)This book discusses applications of pluripotent stem cells to study eye disease in vitro and to create novel therapies for degenerative eye diseases.
Levering: Skaffevare (forvent 14 - 30 hverdage) -
Bemærk: Kan ikke leveres før jul.
The Cytoskeleton: Diverse Roles in a Plant’s Life (Bog, Paperback / softback, Engelsk)This book focuses on the plant cytoskeleton and its various cross-talks with other cellular components leading to its role in plant growth and development.
Levering: Skaffevare (forvent 14 - 30 hverdage) -
Bemærk: Kan ikke leveres før jul.
Regenerative Medicine and Stem Cell Biology (Bog, Paperback / softback, Engelsk)Levering: Skaffevare (forvent 14 - 30 hverdage) -
Bemærk: Kan ikke leveres før jul.
Functional Dissection of Calcium Homeostasis and Transport Machinery in Plants (Bog, Paperback / softback, Engelsk)This book focuses on the significance and implications of Calcium (Ca2+) transport machinery in the plant cell in generating alternating Ca2+ levels and impacting the cell’s physiological, biochemical and developmental processes.
Levering: Skaffevare (forvent 14 - 30 hverdage) -
Bemærk: Kan ikke leveres før jul.
Life Science in Space: Experiments on Board the SJ-10 Recoverable Satellite (Bog, Paperback / softback, Engelsk)This book presents the life science experiments in a space microgravity environment conducted on board the SJ-10 recoverable satellite, which was launched on April 6th 2016 and recovered on April 18th 2016.
Levering: Skaffevare (forvent 14 - 30 hverdage) -
Bemærk: Kan ikke leveres før jul.
Leukemia Stem Cells in Hematologic Malignancies (Bog, Paperback / softback, Engelsk)This book introduces readers to the biology of leukemia stem cells (LSCs) and emphasizes the necessity and importance of targeting LSCs in the treatment of hematopoietic malignancies.
Levering: Skaffevare (forvent 14 - 30 hverdage)